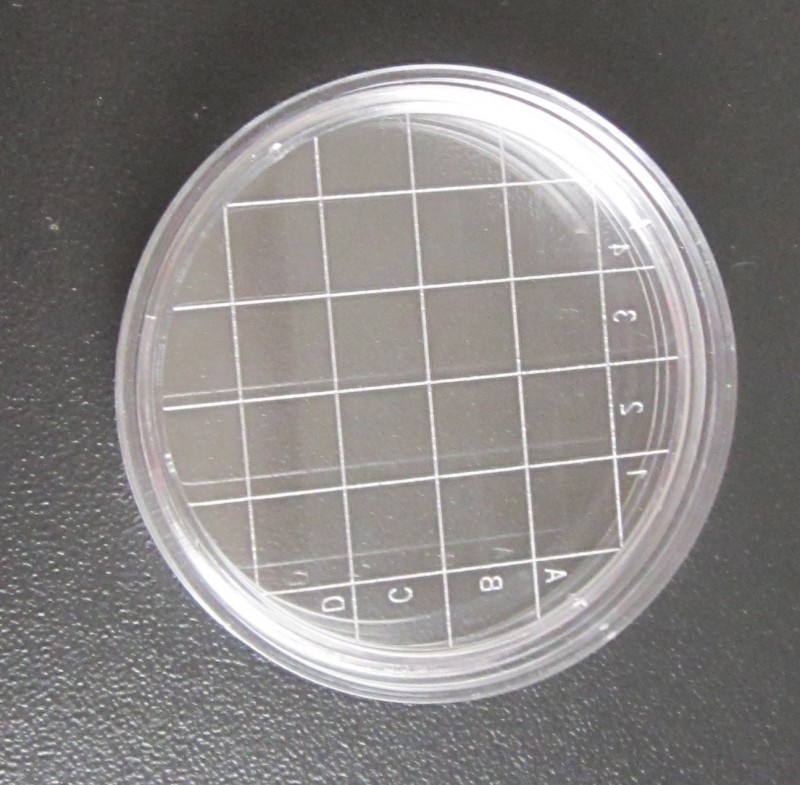
QQ圖片20190322091959

接觸碟(表面微生物檢測用培養皿)
55mm接觸性平皿(接觸碟):用于設備、車間、人員、包裝材料等表面微生物的測定。取代棉簽擦拭法,減少取樣步驟,確保取樣的準確性和安全性。培養基有效表面積為25cm2,符合新版GMP標準所規定的取樣要求。
特點:1.濕熱滅菌,可以重復使用。
2.透光率好,摔不爛。(材質:俗稱金屬玻璃)
3.密閉性好,培養5-7天,培養基不會干裂。
4.培養基有效表面積為25cm2,符合新版GMP表面微生物取樣的要求。 并提供 次性使用接觸碟 TSA預灌裝接觸碟。